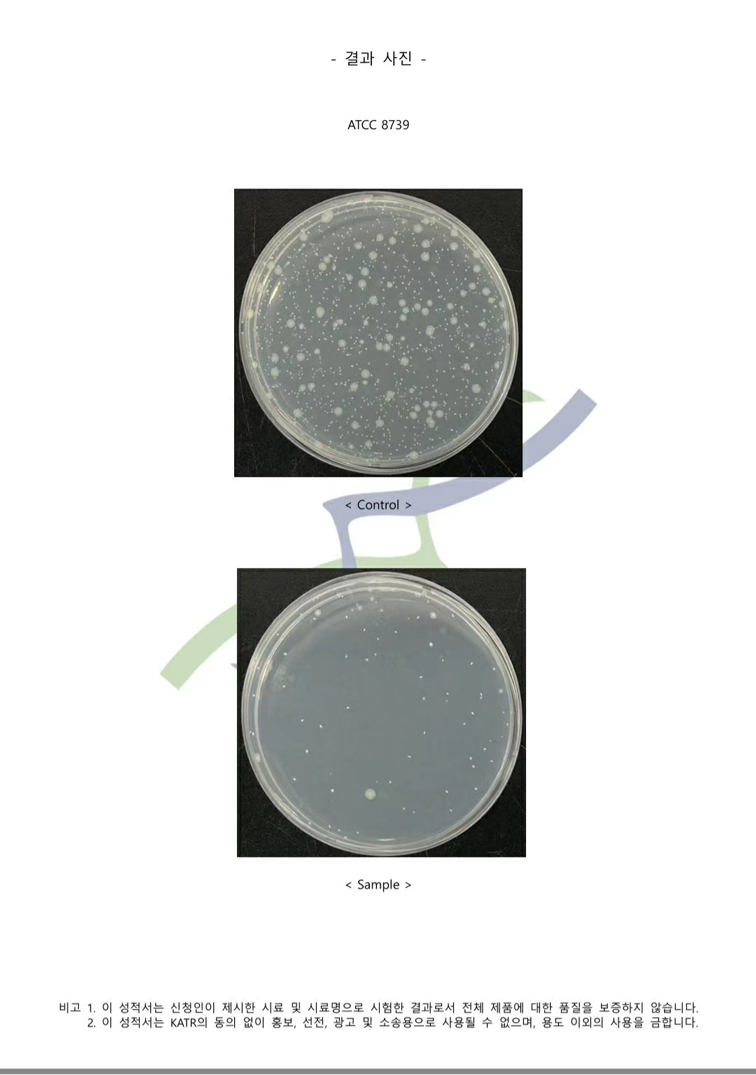

大有來頭的韋柏“抑菌網”
隱形紗窗因為外形美觀、節約空間等諸多優點而備受歡迎,成為家庭裝修的首選。那么紗窗里最重要的東西無非就是紗網了,普普通通的紗網其實也頗有講究。韋柏除了高透網這一火熱產品以外還推出了更加實用型、創新型的新品紗網——“抑菌網”。
首先抑菌這一詞它的含義是指用物理或化學方法抑制住微生物的生長和繁殖。日常生活中細菌和灰塵無處不在,使用抑菌網這一功能性強的紗網可以使我們的紗窗更好地抑住有害細菌繁殖,十分衛生且安全。
下面是我們抑菌網通過的檢測數據:
韋柏抑菌網通過<韓國國家分析實驗研究院,KATR檢測>
檢測結果 :有效抵抗
大腸菌 99.6%
肺炎桿菌 99.9%
綠膿菌 99.6%

下一篇:“韋柏系統紗窗”比普通紗窗好在哪?
上一篇:關于“韋柏” 的品牌故事












